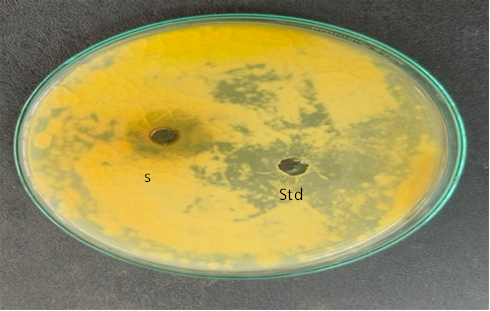

We use cookies to ensure our website works properly and to personalise your experience. Cookies policy

We use cookies to ensure our website works properly and to personalise your experience. Cookies policy
Oxford College of Pharmacy, Bangalore, India.
The primary objective of this research is to synthesize silver nanoparticles using Matricaria chamomilla extract through green synthesis at room temperature and develop novel transdermal patches incorporating these chamomile-mediated silver nanoparticles (AgNPs). The synthesized nanoparticles will be characterized using UV-Visible spectroscopy, FTIR spectroscopy, and particle size analysis. Given chamomile's well-documented antimicrobial and therapeutic properties, this study aims to formulate and evaluate transdermal drug delivery systems that combine the sustained release benefits of transdermal patches with the enhanced antimicrobial efficacy of chamomile-AgNPs. The research seeks to develop an eco-friendly, cost-effective alternative for topical antimicrobial therapy while optimizing patch formulations for improved drug release, skin permeation, and patient compliance.
Transdermal drug delivery systems (TDDS), also known as “Transdermal patches,” are dosage forms designed to deliver a therapeutically effective amount of drug across a patient’s skin. Transdermal delivery not only provides controlled, constant administration of the drug but also allows continuous input of drugs with short biological half-lives and eliminates pulsed entry into the systemic circulation, which often causes undesirable side effects.[1] Thus various forms of Novel drug delivery systems such as Transdermal drug delivery systems, Controlled release systems, Transmucosal delivery systems, etc. emerged.
The common ingredients used for the preparation of TDDS are as follows:
Skin As Site For Transdermal Drug Administration

Fig.1 Structure of skin
The skin of an average adult body covers a surface area of approximately two square meters and receives about one-third of the blood circulating through the body. The skin is a multilayered organ composed of many histological layers. It is generally described in terms of three major tissue layers: the epidermis, the dermis, and the hypodermis. Microscopically, the epidermis is further divided into five anatomical layers with stratum corneum forming the outermost layer of the epidermis, exposing it to the external environment. An average human skin surface is known to contain, on average, 40-70 hair follicles and 200-250 sweat ducts on each square centimeter of skin area.[3] These skin appendages, however, actually occupy, grossly, only 0.1% of the total human skin surface. Even though the foreign agents, especially the water-soluble ones, may be able to penetrate the skin via these skin appendages at a rate that is faster than through the intact area of the stratum corneum, this trans-appendage route of percutaneous absorption has, at steady state, a very limited contribution to the overall kinetic profile of transdermal permeation. Therefore, the transdermal permeation of most neutral molecules can thus, be considered as a process of passive diffusion through the intact stratum corneum in the inter follicular region[4].
Transdermal patch
A transdermal patch, also called a skin patch, is a medicated adhesive patch, which is applied to the surface of the skin to non-invasively deliver a specific dose of the drug through the skin layers and into the systemic circulation over several hours to days after the application. Generally, a transdermal patch consists of five components: (1) liner, protection for the patch during storage, which is removed before application to the skin; (2) drug reservoir where the drug is contained; (3) drug release membrane, which controls drug release from the reservoir through the multi-layers and into the skin; (4) contact adhesive, serves to adhere the patch components to the skin; (5) clear backing protects the patch from outside contamination[5].
Census percentage population in India using Transdermal patches
The Global market for transdermal patches is estimated to increase from $6.7 billion in 2022 to reach $8.8 billion by 2027, at a compound annual growth rate (CAGR) OF 5.6% from 2022 through 2027[6].
TYPES OF TRANSDERMAL PATCHES:
a) Single-layer drug in adhesive: The adhesive layer contains the drug in this type. The adhesive layer not only serves to adhere the various layers together and also responsible for releasing the drug to the skin. The adhesive layer is surrounded by a temporary liner and a backing.
b) Multi-layer drug in adhesive: This type is also similar to the single layer but it contains an immediate drug release layer and the other layer will be a controlled release along with the adhesive layer. The adhesive layer is responsible for the release of the drug. This patch also has a temporary liner layer and a permanent backing[7].
c) Vapour patch: In this type of patch the role of the adhesive layer not only serves to adhere the various layers together but also serves to release vapour. The vapor patches are new to the market, and commonly used for releasing essential oils in decongestion. Various other types of vapor patches are also available in the market which are used to improve the quality of sleep and reduce cigarette smoking conditions.
d) Reservoir system: In this system, the drug reservoir is embedded between an impervious backing layer and a rate-controlling membrane. The drug is released only through the rate-controlling membrane, which can be microporous or nonporous. In the drug reservoir compartment, the drug can be in the form of a solution, suspension, or gel, or dispersed in a solid polymer matrix. The hypoallergenic adhesive polymer can be applied as an outer surface polymeric membrane which is compatible with drug.[8]
e) Matrix system:
i. Drug-in-adhesive system: In this type, the drug reservoir is formed by dispersing the drug in an adhesive polymer and then spreading the medicated adhesive polymer by solvent casting or melting (in the case of hot-melt adhesives) on an impervious backing layer. On top of the reservoir, unmediated adhesive polymer layers are applied for protection purposes.
ii. Matrix-dispersion system: In this type, the drug is dispersed homogeneously in a hydrophilic or lipophilic polymer matrix. This drug-containing polymer disk is fixed onto an occlusive base plate in a compartment fabricated from a drug-impermeable backing layer. Instead of applying the adhesive on the face of the drug reservoir, it is spread along the circumference to form a strip of adhesive rim.
f) Microreservoir system: In this type, the drug delivery system is a combination of reservoir and matrix-dispersion system. The drug reservoir is formed by first suspending the drug in an aqueous solution of water-soluble polymer and then dispersing the solution homogeneously in a lipophilic polymer to form thousands of unreachable, microscopic spheres of drug reservoirs. This thermodynamically unstable dispersion is stabilized quickly by immediately cross-linking the polymer in situ by using cross-linking agents[8,9].
ADVANTAGES OF TDDS
→ Transdermal medication delivers a steady infusion of a drug over an extended period.
→ Transdermal delivery can increase the therapeutic value of many drugs by avoiding specific problems associated with the drug e.g., gastro-intestinal irritation, low absorption, decomposition due to hepatic “first-pass” effect, formation of metabolites that cause side effects, short half-life necessitating frequent dosing, etc. They are non-invasive, avoiding the inconvenience of Parenteral therapy.
→ The drug input can be terminated at any point in time by removing the transdermal patch.
→ The simplified medication regimen leads to improved patient compliance and reduced inter & intra-patient variability.
→ Self-administration is possible with these systems.
→ They can be used for drugs with narrow therapeutic windows.
→ Longer duration of action resulting in a reduction in dosing frequency.
→ Drug therapy may be terminated rapidly by removal of the application from the surface of the skin[10].
DISADVANTAGES OF TDDS
→ The drug must have some desirable physicochemical properties for penetration through stratum corneum and if the drug dose required for therapeutic value is more than 10mg/day, the transdermal delivery will be very difficult.
→ Only relatively potent drugs are suitable candidates for TDDS because of the natural limits of drug entry imposed by the skin’s impermeability.
→ Some patients develop contact dermatitis at the site of application for one or more of the system components, necessitating discontinuation.
→ Clinical need is another area that has to be examined carefully before a decision is made to develop a transdermal product.
→ The barrier function of the skin changes from one site to another on the same person, from person to person, and with age.[11]
Ideal molecular properties for transdermal drug delivery
→ An adequate solubility in lipid and water is necessary for better penetration of the drug (1mg/ml).
→ Optimum partition coefficient is required for good therapeutic action.
→ A low melting point of the drug is desired (<2000 C )
→The pH of the saturated solution should be between 5 to 9[12].
Advantages of herbal transdermal patches over others: Herbal transdermal patches are preferred by some people for several reasons:
1. Convenient delivery: They provide an easy, non-invasive way to administer herbal compounds.
2. Sustained release: Patches can deliver a steady dose of herbs over an extended period, potentially providing longer-lasting effects.
3. By-pass digestive system: By delivering herbs through the skin, patches avoid potential degradation in the digestive tract and first-pass metabolism in the liver.
4. Reduced side effects: Bypassing the digestive system may reduce gastrointestinal side effects associated with oral herbal supplements[13].
5. Improved compliance: Patches are easy to use and typically require less frequent application than oral supplements, which may improve treatment adherence.
6. Localized treatment: For some conditions, patches can deliver herbs directly to the affected area.
7. Avoid taste issues: Some people find the taste of herbal supplements unpleasant, which is not an issue with patches.
CHARACTERISTIC FEATURES OF HERBAL TRANSDERMAL PATCHES:
1. Mechanism of action: Transdermal patches work by allowing herbal compounds to pass through the skin and into the bloodstream. The skin acts as a semi-permeable membrane, allowing certain molecules to pass through. The herbs are typically mixed with penetration enhancers to improve absorption.
2. Types of herbs commonly used: Some herbs frequently used in transdermal patches include:
3. Potential limitations:
4. Regulatory status: In many countries, herbal transdermal patches are regulated as dietary supplements rather than drugs, which means they may not undergo the same rigorous testing for safety and efficacy as pharmaceutical patches.
5. Comparison to other delivery methods: While patches offer advantages over oral supplements, they may not be as fast-acting as sublingual or inhaled herbal preparations. They also typically deliver lower doses.
6. Combination with other therapies: Some people use herbal patches in conjunction with other treatments, such as acupuncture or massage therapy, as part of a holistic approach to health.
7. Duration of effect: Depending on the specific product, patches may be designed for short-term use (a few hours) or extended wear (up to several days)[16].
Transdermal patches using chemical methods for drug delivery have several drawbacks:
1. Limited drug selection: Not all drugs are suitable for transdermal delivery due to molecular size, solubility, or other physicochemical properties.
2. Skin irritation: Chemical penetration enhancers used to improve drug absorption can cause skin irritation, rashes, or allergic reactions in some patients.
3. Variable absorption: Factors like skin thickness, hydration, and temperature can affect drug absorption rates, leading to inconsistent dosing.
4. Slow onset of action: Compared to oral or intravenous administration, transdermal patches often have a slower onset due to the time needed for the drug to penetrate the skin.
5. Potential for overdose: If the patch is damaged or exposed to heat, it may release the drug too quickly, potentially leading to overdose.
6. Adhesion issues: Patches may fall off or lose effectiveness if they don't adhere properly to the skin, especially during physical activity or sweating.
7. Cost: Transdermal patches are often more expensive to manufacture than traditional oral medications.
8. Limited dosage control: Once applied, it's difficult to adjust the dose or stop drug delivery immediately if needed.
9. Skin barrier function: The stratum corneum naturally resists drug penetration, which can limit the effectiveness of some transdermal formulations.
10. Drug metabolism in the skin: Some drugs may be partially metabolized in the skin before reaching systemic circulation, reducing bioavailability[18].
SILVER NANOPARTICLES
Silver nanoparticles are "oligodynamic" with both bactericidal and bacteriostatic properties. Several techniques have been developed for the production of silver nanomaterials including chemical reduction, liquified solution oxidation-reduction, the template (ligand-based reaction for preparing nanofibers within the opening of microporous membrane) method, electro-synthetic reduction, supersonic-assisted reduction, light-induced or light-catalytic reduction, microwave pyrolysis synthesis, radiation emission reduction, the nano-emulsion method, biosynthetic method, etc. However, these chemical methods have been reported along with various stumbling blocks, including the use of toxic agents and the formation of unpredictable by-products, which can be prone to human health consequences of nature and the world. Currently, progress is needed to develop eco-friendly technology.
Several techniques have been developed for the production of silver nanomaterials including chemical reduction, liquified solution oxidation-reduction, electro-synthetic reduction, supersonic-assisted reduction, light-induced or light-catalytic reduction, microwave pyrolysis synthesis, radiation emission reduction, nano-emulsion method, green synthesis method, etc. but the chemical methods have been reported along with various stumbling blocks, including the use of toxic agents.[26]
Silver Nanoparticles (AgNPs) are booming because of their unique physical, chemical, and biological properties. Silver is known for its antibacterial properties from ancient times it has been used for various applications like water and air purification, food, and clothing. This may exhibit its activity by capabilities not exerted by ionic silver because of its small size and large surface area. AgNPs display a broad spectrum (anti-bacterial, anti-fungal, anti-viral, anti-neoplastic) activity, which has made them extremely famous in the multiple range of marketed products and because of their broad range of applications many synthetic routes have been developed for the synthesis of AgNPs. In the synthesis of AgNPs. Plant extract of reducing Ag to Agº capping or stabilizing of particles.[27
DRUG PROFILE:
CHAMOMILE


Fig.02 Chamomile plant
PLANT DESCRIPTION:
Ray florets (Outer “petals”)
Disc florets(Centre)
Aroma: Sweet, apple-like scent, especially noticeable when the flowers are crushed.
The flowers are rich in bioactive compounds, including[20,21];
Chamomile's therapeutic properties are attributed to its rich phytochemical profile:
1. Essential Oil Components: α-bisabolol and its oxides, Chamazulene (responsible for the blue color in some extracts), Farnesene, Spiroethers (e.g., en-in-dicycloethers)
2. Flavonoids: Apigenin and its glycosides, Luteolin, Quercetin
3. Coumarins: Herniarin, Umbelliferone
4. Phenolic Acids: Chlorogenic acid, Caffeic acid
5. Terpenoids: Sesquiterpenes, Sesquiterpene lactones
These compounds contribute to chamomile's various medicinal properties, including anti-inflammatory, antioxidant, and mild sedative effects[22]
MECHANISM OF ACTION FOR ANTIFUNGAL ACTIVITY OF CHAMOMILE

Chamomile exhibits antifungal activity through several mechanisms:
a) Membrane Disruption: Essential oils, particularly α-bisabolol, can disrupt fungal cell membranes, leading to increased permeability and eventual cell death.
b) Enzyme Inhibition: Some compounds in chamomile inhibit crucial fungal enzymes, interfering with cell wall synthesis and other vital cellular processes.
c) Oxidative Stress Induction: Certain constituents generate reactive oxygen species (ROS) in fungal cells, causing oxidative damage to cellular components.
d) Biofilm Inhibition: Chamomile extracts have shown the ability to inhibit fungal biofilm formation, which is crucial for fungal colonization and resistance.
2. OBJECTIVES
3. REVIEW OF LITERATURE
Sanjay Gupta et.al.,(2010),[17] Explained that Chamomile (Matricaria chamomilla L.) is a well-known medicinal plant species from the Asteraceae family often referred to as the “star among medicinal species.” Nowadays it is a highly favored and much used medicinal plant in folk and traditional medicine. Its multitherapeutic, cosmetic, and nutritional values have been established through years of traditional and scientific use and research. Chamomile has an established domestic (Indian) and international market, which is increasing day by day. The plant that is available on the market many times is adulterated and substituted by close relatives of chamomile. This article briefly reviews the medicinal uses along with botany and cultivation techniques. Since chamomile is a rich source of natural products, details on the chemical constituents of essential oil and plant parts as well as their pharmacological properties are included. Furthermore, particular emphasis is given to the biochemistry, biotechnology, market demand, and trade of the plant. This is an attempt to compile and document information on different aspects of chamomile and highlight the need for research and development.
Kandarp Mavani & Mihir Shah et.al., (2013)[32], Developed research on the Chemical reduction of silver nanoparticles AgNO3 using NaBH4.Chemical reduction of silver nanoparticles involves the reduction of a silver salt such as silver nitrate with a reducing agent like sodium borohydride in the presence of a colloidal stabilizer. Sodium borohydride has been used with Polyvinyl alcohol (PVA), Polyvinyl pyrrolidone (PVP), Albumin (BSA), citrate, and cellulose which are used as stabilizing agents. The Ag solution became yellowish because of the absorption wavelength at 386nm. UV visible spectral analysis is the primary confirmation for the formation of silver nanoparticles. The silver nanoparticles were estimated to be 10 to 20nm in diameter. Thus, Silver nanoparticles' absorption and scattering properties can be tuned by controlling the particle size, shape, and the local refractive index near the particle surface. As Silver nanoparticles have unique optical, electrical, and thermal properties, they are been incorporated into products that range from photovoltaics to biological and chemical sensors. The study also deals with various applications of silver nanoparticle diagnostic, antibacterial, conductive, and optical applications.
Magdalena Parlinska-Wojtan et. al.,(2016)[33], explained the green synthesis method using camomile extract was applied to synthesize silver nanoparticles to tune their antibacterial properties merging the synergistic effect of chamomile and Ag. Scanning transmission electron microscopy revealed that camomile extract (CE) consisted of porous globular nanometer-sized structures, which were a perfect support for Ag nanoparticles. The Ag nanoparticles synthesized with the camomile extract (AgNPs/CE) of 7 nm average sizes, were uniformly distributed on the CE support, contrary to the pure Ag nanoparticles synthesized with glucose (AgNPs/G), which were over 50 nm in diameter and strongly agglomerated. The energy-dispersive X-ray spectroscopy chemical analysis showed that camomile terpenoids act as a capping and reducing agent being adsorbed on the surface of AgNPs/CE enabling their reduction from Ag+ and preventing them from agglomeration. Fourier transforms infrared and ultraviolet-visible spectroscopy measurements confirmed these findings, as the spectra of AgNPs/CE, compared to pure CE, did not contain the 1109 cm−1 band, corresponding to –C–O groups of terpenoids, and the peaks at 280 and 320 nm, respectively. Antibacterial tests using four bacteria strains showed that the AgNPs/CE performed five times better compared to CE AgNPs/G samples, reducing totally all the bacteria in 2 hrs.
Shah MKA, Azad AK et.al.,[28] studied the effect of surfactants and polymers on the physicochemical properties, in-vitro release, and permeation of NPs was investigated. The prepared NPs containing various surfactants and polymers (e.g., Tween 20 (T20), Tween 80 (T80), sodium lauryl sulfate (SLS), propylene glycol (PG), and Polyethylene glycol-4000 (PEG-4000)) were physiochemically evaluated for size, zeta potential, drug content, percent entrapment efficiency, in-vitro release, and permeation across rats' skin. A Franz diffusion cell was used for evaluating the in-vitro release and permeation profile. The voriconazole-loaded NPs were investigated for antifungal activity against Candida albicans (C. albicans). The prepared NPs were in the nano range (i.e., 160-500 nm) and positively charged. Images taken by a scanning electron microscope showed that all prepared NPs were spherical and smooth. The drug content of NPs ranged from 75% to 90%. Nanoparticle formulations exhibited a good in-vitro release profile and transported voriconazole across the rat's skin in a slow control release manner. The NPs containing SLS, T80, and PG exhibited the best penetration and skin retention profile. In addition, the formulation exhibited a potential antifungal effect against C. albicans. It was concluded that the development of chitosan NPs has great potential for the topical delivery of voriconazole against fungal infection.
Johnson I and Joy Prabu H et.al., (2015)[34], explained the method for the biosynthesis of silver nanoparticles. The main reaction occurring is reduction. Silver nanoparticles (AgNPs) have been used for infection prevention in the medical field. This method is good for anti-microbial activity against bacteria, viruses, and other microorganisms and hence clearly enhances the medicinal usage of AgNPs. This type of green biosynthesis of nanoparticles has received increasing attention. In the process of synthesizing AgNPs, it was observed that a rapid reduction of silver ions led to the formation of stable crystalline AgNPs in the solution. Plant extracts from Cycas circinalis, Ficus amplissima, Commelina benghalensis, and Lippia nodiflora were used for the synthesis of AgNPs from silver nitrate solution. AgNPs were characterized by different techniques. UV spectral analysis gives primary conformation of the formation of silver nanoparticles by a visual color change of solution, FTIR measurement was carried out to identify the possible biomolecules responsible for capping and efficient stabilization of Ag nanoparticles synthesized using plant extracts Scanning electron microscopy provided further insight into the morphology and size details of the AgNPs. The XRD spectra analysis was used to confirm the crystalline nature of the AgNPs synthesized. In this study, it is found that the leaves of medicinal plants were good sources for the synthesis of AgNPs and have many advantages.
Jose Vega-Baudrit,et.al.,(2019)[35].This review presents the main methods of chemical reduction for the preparation of silver nanoparticles, such as the preparation of silver particles using NaBH4 and ascorbic acid as a reducing and stabilizing agent, the preparation of silver particles using PVP as a reducing agent and the preparation of silver particles using DMF as a reducing agent. In addition, the main methods of characterization of silver nanoparticles are presented according to the size and morphology of the nanoparticles and the properties of surface and stability. Finally, the applicability of silver nanoparticles as an antibacterial agent is demonstrated.
Nusrat Ahmad et.al., (2024)[36]. The review focused on the synthesis of silver nanoparticles (AgNPs) from Aspergillus niger, Aspergillus flavus, and Penicillium chrysogenum using a green approach and to test the antifungal activity of these synthesized AgNPs against a variety of pathogenic fungi. The characterization of samples was done by using UV-visible spectroscopy, SEM (scanning electron microscopy), FTIR (Fourier transmission infrared spectroscopy), and XRD (X-ray diffractometry). The investigation confirmed the creation of AgNPs by the fungi Aspergillus niger, Aspergillus flavus, and Penicillium chrysogenum, as evidenced by prominent plasmon absorbance bands at 420 and 450 nm. The biosynthesized AgNPs were 80-100 nm in size, asymmetrical in shape, and became spherical to sub-spherical when aggregated. The agar well diffusion method was performed to evaluate the antifungal activity of AgNPs against various plant pathogenic fungi. An efficient and strong antifungal activity was shown by these biosynthesized nanoparticles against serious plant pathogenic fungi, viz. Aspergillus terreus, Fusarium oxysporum, Penicillium citrinum, Rhizopus stolonifer and Mucor mucedo. The biosynthesized AgNPs at various concentrations caused a significant zone of inhibition in the test fungal pathogens. Silver nanoparticles (AgNPs) biosynthesized from Aspergillus niger at highest concentrations showed maximum zone of inhibition against Penicillium citrinum (19.33 ± 0.57 mm) followed by Rhizopus stolonifer (17.66 ± 0.57), Aspergillus terreus (16.33 ± 1.54 mm), Fusarium oxysporum (14.00 ± 1.00 mm) and Mucor mucedo (13.33 ± 1.15 mm) respectively. Therefore, the findings indicate that silver nanoparticles could play a significant role in managing diverse plant diseases caused by fungi.
Suksaeree J.et.al.,[37] This review gives an idea about how herbal transdermal patches were prepared by incorporating Lysiphyllum strychnifolium stem extract into optimized polyvinyl alcohol (PVA) blended film as a matrix layer for controlled drug release. A microwave-assisted technique was used for extracting L. strychnifolium stems. The optimum extraction conditions predicted by the Design-Expert® program were 80% ethanol solvent, 800 W power, 20 s extraction time, and one extraction cycle. The prediction was accurate with a low percentage error. The total phenolics and total flavonoids of the herbal extract were 515.48 ± 43.08 and 59.78 ± 2.11 mg CE/g extract, respectively. Antioxidant activity of the herbal extract was 1.85 ± 0.12 and 0.533 ± 0.056 μg/ml from DPPH and FRAP assay, respectively. Nitric oxide scavenging assay of the herbal extract gave an IC50 of 114.42 ± 22.39 μg/mL. The blank-optimized PVA blended film and herbal transdermal patches had desirable properties and compatible, homogeneous, smooth, and compact blended ingredients. The herbal transdermal patches could control the release and skin permeation behavior of astilbin from the matrix layer. The kinetics of the release and permeation behavior of astilbin were fitted to the Korsmeyer–Peppas and zero-order models, respectively. Thus, the transdermal patches containing L. strychnifolium extract are suitable for use in herbal medicine applications.
4. MATERIALS AND METHODS
4.1. Drug and Chemicals
DRUG: The crude extract obtained from the dried flowers of Matricaria chamomilla.
CHEMICALS
4.2. Plant collection and authentication
The flowers of Matricaria chamomilla were purchased from Green Aura Garden, Thiruvananthapuram, Kerala. The flowers were authenticated by Central Ayurveda Research Institute, Bangalore – 560109.
The flowers purchased are then carefully air-dried in a shaded, well-ventilated area for 7-10 days until the flower heads easily crumble.

Fig.03 Dried Chamomile flowers

Fig.04 Processed chamomile flowers
4.3.Preparation of crude extract
To extract 20 grams of Matricaria chamomilla, flowers were crushed into a coarse powder with the help of a mortar & pestle. Then the extract was prepared by soaking the finely grounded powder in 100 ml of 95% aqueous ethanol and 100 ml of distilled water, and the contents were well mixed and kept for maceration for 5 days in a dark place with occasional stirring. After maceration evaporate the ethanol using a steam evaporator (temperature maintained at 35 0C). Then, it cooled and filtered by using a muslin cloth. The obtained extract was used for further processing.[26]

Fig.05 Coarse powder

Fig.06 Macerated product
4.4.Synthesis of silver nanoparticles
For silver nanoparticle synthesis. 1mM aqueous solution of silver nitrate (AgNO3) was prepared. 10 ml of aqueous extract of Matricaria chamomilla was transferred into a beaker and placed on the magnetic stirrer with a hot plate. Then 100ml of 1mM silver nitrate solution was added dropwise and stirred continuously under 5000 rpm and the temperature was maintained at 70°C- Then color changes in the solution were monitored at regular intervals and the color changes from greyish green to brownish indicates the generation of silver nanoparticles.[25]
4.5. Characterization of Silver Nanoparticles
4.5.1 UV-Visible spectrophotometric analysis
Silver nanoparticles were prepared and it was observed by measuring the absorption spectrum in the wavelength given at a range of 200-800nm SHIMADZU UV- 1800 spectrophotometer. The spectrum was recorded at the maximum absorption wavelength was determined.[29]
4.5.2. Particle Size Distribution and Polydispersity Index
The mean particle size is calculated using a great version of the ZETASIZER 7.13 instrument that was created by Malvern Instrument. The UK. The size of the particle is obtained at 25° C at a 90° angle with (n=10) has been recorded. Then. PDI (polydispersibility index) is found to measure the average mean size by observing its diameter and distribution in light intensity, weighed size of bulk population obtained from Proton Correlation Spectroscopy analysis[29,30].
4.5.3. Zeta Potential
The potential of the particle that is synthesized is measured by Malvern zeta sizer version 23(Malvern Instrument. UK). An adequate sample (50-100µl) has been diluted with 5 ml of water (0.45 µm) and injected into the electrophoretic cell of the instrument to calculate the Potential value.
4.5.4.Fourier Transform Infrared (FTIR) spectroscopy
The FTIR spectrum of the biosynthesized silver product was recorded on an FTIR instrument mode Nicolet 6700 spectrometer at a resolution of 4 cm−1 attachment. All measurements were carried out in the range of 400–4000 cm−1 at a resolution of 4 cm−1.
4.5.5. Antifungal activity of chamomile silver nanoparticles
The in-vitro antifungal activity of different formulations was assessed using the cup-plate technique).[28] Here's how the experiment was conducted:
1. Preparation of Sabouraud Dextrose Agar Media:
2. Inoculation and Placement of Samples:
3. Incubation and Measurement:
This entire process was repeated three times (triplicate) to ensure accurate and reproducible results.[23]
4.6.Preparation of transdermal patches
Matrix-type transdermal patches of Chamomile were prepared by solvent casting techniques. Transdermal casting molds having a surface area of 40 cm² were fabricated for casting the patches. Take the appropriate amount of solvent and dissolve the polymer into it under continuous stirring and add separately prepared drug solution into the polymer solution under continuous stirring. Add Plasticizer into the above solution under continuous stirring. Add Permeability enhancer into the above solution under continuous stirring and sonicate the final solution to remove the bubble. Cast the batch into the mold and keep it for drying in an oven at a temperature of 450C for 5 hours. After the patches are dried, they are removed and evaluated.[26.27]
Table 1: Composition of Transdermal Patch (250mg)
|
Sr. No |
Ingredients |
Quantities |
|||
|
|
|
F1 |
F2 |
F3 |
F4 |
|
1 |
Chamomile AgNPs |
2ml |
2.25ml |
2ml |
2.5ml |
|
2 |
Guar Gum |
35mg |
40mg |
45mg |
50mg |
|
3 |
PVA |
140mg |
150mg |
130mg |
160mg |
|
4 |
PVP K-30 |
90mg |
100mg |
85mg |
105mg |
|
5 |
Propylene glycol |
0.75ml |
0.8ml |
0.7ml |
0.85ml |
|
6 |
Distilled Water |
q. s |
q. s |
q. s |
q. s |
4.7. Evaluation of transdermal patches
4.7.1 Physical Evaluation
Physical parameters such as color, appearance, and consistency were checked visually.
4.7.2 Appearance
Color is important for patient compliance. The prepared patches were inspected visually for clarity, color, and the presence of any particles.[28]
4.7.3 Measurement of PH
A digital pH meter was used to determine the pH of the formulation. The surface pH of the prepared transdermal patch was determined using a pH meter. The patch was slightly wet with the help of water. The pH was measured by bringing the electrode in contact with the surface of the patch. The procedure was performed in triplicate and an average with standard deviation was reported.[28]
4.7.4 Weight variation
Four-centimeter square of the patch was cut at three different places from the casted film. The weight of each film was taken and weight variation was calculated.
4.7.5 Patch thickness
The prepared transdermal patches were tested for uniformity of thickness. The thickness of the prepared patches was measured using a digital vernier caliper with a least count of 0.01 mm at different spots of the patch. The thickness was measured at three different spots of the patches an average was taken and SD was calculated.[29]
4.7.6 Folding endurance
Folding endurance was determined by repeated folding of the patch at the same place till the strip broke. The number of times the patch is folded without breaking was computed as the folding endurance value.[29]
4.7.7 Drug Content
A drug content test of the patch was carried out by dissolving the 4 cm² patch in 100 ml of Ph 7.4 phosphate buffer.[30] The prepared solution was filtered and then measured spectrophotometrically at lamda max of 279 nm. The determination was carried out in triplicate for all the formulations and the average with standard deviation was recorded.[32]
5. RESULTS AND DISCUSSION
5.1 Extraction of plant material
20 grams of Matricaria chamomilla, flowers were weighed and crushed into a coarse powder with the help of a mortar & pestle. Then the extract was prepared by soaking the finely grounded powder in 100 ml of 95% aqueous ethanol and 100 ml of distilled water, and the contents were well mixed and kept for maceration for 5 days in a dark place with occasional stirring. After maceration evaporate the ethanol using a steam evaporator (temperature maintained at 35 0C). Then, it was cooled and fltered using a muslin cloth to get the extract.



Fig.07 chamomile extract
5.2 Green synthesis of silver nanoparticles
Green synthesis of silver nanoparticles was prepared from Chamomile flower plant extract. The silver nanoparticles are prepared at a concentration of 1mM. On mixing plant extract with the silver nitrate solution, a change in the color from pale yellow to dark brown was observed, indicating the reduction of silver ions and the formation of silver nanoparticles.


1mM Silver Nitrate solution Processing of AgNPs


Synthesis of silver nanoparticles Centrifugation of AgNPs

Loading of Chamomile drug extract into AgNPs
Fig.08 Preparation of AgNPs
5.3 Characterization of silver nanoparticles
5.3.1 By UV Spectroscopy
The UV spectrum of AgNPs was measured at the range of 200-600 nm and the development of AgNPs was confirmed by UV-vis spectroscopy at 424 nm where a specific peak was found. (UV Spectrum of AgNPs).

Fig.09 UV-spectrum of AgNPs
5.3.2 Determination of Particle Size, Zeta Potential
The average particle size was found when operating on a zeta sizer instrument in a dynamic light scattering system. The mean particle size was 410.7nm, indicating that silver ions have formed into silver nanoparticles. The silver nanoparticle’s polydispersity index(PDI) was found to be 0.555. By this method, the zeta potential was observed to be -8.4mV.

Fig.10 Report of AgNPs particle size and PDI

Fig.11. Report of AgNPs zeta potential
5.3.3 FTIR STUDIES

Fig.12 FTIR report of chamomile-extract

Fig.13 FTIR report of formulation
TABLE -2 Interpretation of FTIR reports
|
SR. NO |
FREQUENCY RANGE (CM-1) |
FUNCTIONAL GROUP |
|
1 |
3500 – 3000 |
Primary amines (N-H) |
|
2 |
3000 – 2500 |
Amine salt (N-H) |
|
3 |
2500 – 2000 |
Azide (N=N=N) |
|
4 |
2000 – 1500 |
Imine / oxime (C=N) |
|
5 |
1500 - 1200 |
Sulphonamide, Carboxylic acid, Fluoro compounds, nitro compounds |
|
6 |
1200 – 1000 |
Primary alcohols, sulfoxide |
|
7 |
1000 – 800 |
Halo compounds, alkenes |
|
8 |
800 - 100 |
Flavonoids, benzene derivatives |
Fig. 12 and 13 indicate the FTIR spectrum for chamomile, silver nanoparticles, and Excipients respectively. The functional peaks were observed in the physical mixture, consistent with those found in the individual spectra of the samples. This indicates no changes in the characteristic functional peaks. Therefore, the results confirm that the drug and the excipients are compatible.
5.3.4 Formulation of Transdermal Patches
Transdermal patches were prepared using the solvent-casting method. Gaur gum was dissolved in water and kept for hydration for 1hr. PVA and PVP K-30 were dissolved in distilled water separately Later these polymeric solutions were mixed. Chamomile AgNPs were then added to the above solution by stirring for 15 minutes with a magnetic stirrer. Propylene glycol was added as a plasticizer. This solution was then sonicated for 30 min to remove air bubbles and also placed in a desiccator if necessary: The solution was poured into a glass mold of size 10*4 cm in length and breadth and was dried in a hot air oven at 45°C for 5 hrs. The dried films were carefully removed and checked for any cracks and cut into square pieces of sides 4*4 cm2.


Polymers dissolved in solvent The formulation was poured into the mold.

Fig.14 Formulation of transdermal patches
5.3.5 Evaluation of Transdermal Patches
Physical Evaluation
The prepared transdermal patches are evaluated for their physical appearance, color, odor, weight uniformity, thickness uniformity, surface pH, flatness test, texture, and drug content uniformity.
Table 3 Visual evaluation of chamomile incorporated AgNPs transdermal patches.
|
Formula |
Color |
Odor |
Texture |
Flexibility |
|
F1 |
Pale yellow |
Odorless |
Flat surface |
flexible |
|
F2 |
Golden yellow |
Odorless |
Flat surface |
flexible |
|
F3 |
Light yellowish-brown |
Odorless |
Flat surface |
flexible |
|
F4 |
Golden yellow |
Odorless |
Flat surface |
flexible |
Determination of pH
The pH of the antifungal transdermal patches was consistently within the desired range, demonstrating that the formulations are likely to be stable and effective. The results indicate that the pH measurement process is reliable and that the transdermal patches are well-prepared for further testing and potential use.
Table 4 Results of pH
|
SR.NO |
FORMULATION |
TRIAL |
pH |
S.D |
|
1 |
F1 |
1 |
6.7 |
6.7 ± 0.1 |
|
2 |
6.6 |
|||
|
3 |
6.8 |
|||
|
2 |
F2 |
1 |
6.5 |
6.5 ± 0.1 |
|
2 |
6.4 |
|||
|
3 |
6.6 |
|||
|
3 |
F3 |
1 |
6.8 |
6.8 ± 0.1 |
|
2 |
6.9 |
|||
|
3 |
6.7 |
|||
|
4 |
F4 |
1 |
6.6 |
6.6 ± 0.1 |
|
2 |
6.7 |
|||
|
3 |
6.5 |
Thickness
With the help of screw gauze, the thickness of the films was measured and the average thickness was noted. The thickness results are given in Table 5. The result indicates that there was not much difference in the thickness within the formulations. The order of the thickness of films is F3< F2< F1< F4.
Table- 5 Results of patch thickness
|
Sr. no. |
Formulation |
Average Thickness (mm) |
|||
|
Trial-1 |
Trial-2 |
Trial-3 |
Mean ± S.D* |
||
|
1 |
F1 |
0.222 |
0.227 |
0.224 |
0.224 ± 0.002 |
|
2 |
F2 |
0.219 |
0.221 |
0.223 |
0.221 ± 0.002 |
|
3 |
F3 |
0.218 |
0.215 |
0.217 |
0.217 ± 0.002 |
|
4 |
F4 |
0.296 |
0.291 |
0.297 |
0.295 ±0.003 |
*Standard deviation, n=3
Weight Uniformity
Drug-loaded patches (4 x 4 cm2) were tested for uniformity of weight and the results of weight uniformity are given in Table 5. Lesser S.D. values indicate that the patches were uniform. All formulations demonstrated mean weights close to the target weight of 250 mg, with deviations less than 1% in either direction.
Formulation F3 exhibited the lowest mean weight (249.2 mg), while F4 showed the highest mean weight (251.5 mg). The range of mean weights spanned 2.3 mg.
Formulations F1 and F2 had mean weights (249.8 mg and 250.6 mg, respectively) closer to the target of 250 mg.
As indicated by the standard deviation, the weight variation was highest for F3 (1.40 mg) and F1 (1.27 mg), which coincidentally had the lowest mean weights.
Formulations F2 and F4 demonstrated identical standard deviations (0.93 mg), indicating similar levels of consistency in their manufacturing processes, despite differences in their mean weights.
Table 6 Results for weight uniformity
|
Sr. No. |
Formulation |
Average Weight(mg) |
|||
|
Trial-1 |
Trial-2 |
Trial-3 |
Mean ± S.D* |
||
|
1 |
F1 |
248.7 mg |
251.2 mg |
249.5 mg |
249.8 ± 1.27 |
|
2 |
F2 |
250.3mg |
249.8 mg |
251.6 mg |
250.6 ± 0.93 |
|
3 |
F3 |
247.9mg |
250.7 mg |
249.1 mg |
249.2 ± 1.40 |
|
4 |
F4 |
251.8 mg |
250.5 mg |
251.5 mg |
251.5 ± 0.93 |
*Standard deviation, n=3
Drug content
The drug content of the film was carried out to ascertain that the drug was uniformly distributed into the formulation. The size 2 X 2 cm2 film was cut and placed in a volumetric flask. 10ml of methanol was added and the contents were stirred in a shaker bath for 24 h to dissolve the film. Subsequent dilutions were made with phosphate buffer (pH 7.4). The absorbance of the solution was measured against the corresponding blank solution at 237 nm using a UV -VIS spectrophotometer. The results obtained are represented in Table 6. From the results obtained (i.e., lowest S.D. values), it was clear that the drug (Chamomile AgNPs) was properly distributed in the film formulations. Hence it was concluded that the drug was uniformly distributed in all the formulations. The results are reported in Table 7.
Table-7 Results for % Drug content
|
SR. NO |
FORMULATION |
TRIAL |
ABSORBANCE (nm) |
DRUG CONTENT (mg) |
AVERAGE DRUG CONTENT |
% DRUG CONTENT |
S.D |
|
1. |
F1 |
1 |
0.852 |
248.3 |
248.5 |
99.40 |
± 0.82 |
|
2 |
0.855 |
249.1 |
|||||
|
3 |
0.851 |
248.1 |
|||||
|
2 |
F2 |
1 |
0.848 |
247.2 |
247.8 |
99.12 |
± 1.05 |
|
2 |
0.852 |
248.3 |
|||||
|
3 |
0.850 |
247.9 |
|||||
|
3 |
F3 |
1 |
0.856 |
249.4 |
249.2 |
99.68 |
± 0.76 |
|
2 |
0.854 |
248.8 |
|||||
|
3 |
0.855 |
249.1 |
|||||
|
4 |
F4 |
1 |
0.853 |
248.6 |
249.5 |
99.56 |
± 0.91 |
|
2 |
0.856 |
249.4 |
|||||
|
3 |
0.854 |
248.8 |
5.4 ANTIFUNGAL ACTIVITY
Candida albicans were inoculated on media (90 mm). Test compounds: Sample (25µl) and Standard Ketoconazole (50µl) Candida albicans were added to the 5mm well on agar plates. The treated plates with Candida albicans were incubated at 24-30°C for 24- 72 hrs. The treated plates were observed for the zone of inhibition around the wells.
Table 8: Inhibitory activity of test compounds against test organisms
|
Test Organisms |
Test Compounds |
Conc. per well |
Zone of inhibition (mm) |
Figure reference number |
|
Candida albicans |
Ketoconazole |
100 µg/ml |
14-18 |
Figure 15 |
|
Chamomile |
- |
7 |
Fig 14 zone of inhibition
Conclusion: The zone of inhibition observed against the test compound and standard are summarized in Table 8 and Figure 15. The sample has shown inhibitory activity against Candida albicans.
The green synthesis of AgNPs using chamomile extract transdermal patch has shown promising anti-fungal activity against Candida albicans species.
6. CONCLUSION
The purpose of this study was to develop an anti-fungal transdermal patch incorporated with chamomile silver nanoparticles. Herbal cosmetic products that were developed were environment-friendly and non-toxic. The green synthesis of AgNP using Matricaria Chamomile has been promising anti-fungal activity which was confirmed by the anti-fungal assay of the zone of inhibition of the Candida albicans species. The transdermal patch formulation prepared containing silver nanoparticles of Chamomile extract showed good activity. F4 formulation was considered the better formulation among the four formulations prepared as it showed good drug uniformity, thickness, desired pH, etc. The anti-fungal activity of the F4 was found to be satisfactory which proves the formulated transdermal patch to have a potent anti-fungal effect and better patient compliance when compared to expensive synthetic antifungal patches.
REFERENCES






Kruthika S G, Manohar Reddy, Madhushree R, Kruthic Revanth G, Iyswarya G M, Krishna R, Formulation and Evaluation of Anti-Fungal Activity of Chamomile Silver Nanoparticles Incorporated in Transdermal Patches, Int. J. of Pharm. Sci., 2025, Vol 3, Issue 12, 1843-1868. https://doi.org/10.5281/zenodo.17882701
 10.5281/zenodo.17882701
10.5281/zenodo.17882701